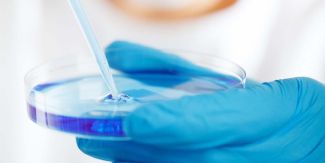
Dettaglio su piastra di Petri tenuta da mano con guanto

Mucins, Mucus and Mucosa - A Multidisciplinary Perspective across Biology, Biotechnology and Biomaterials
(English below) Il Dipartimento di Biotecnologie Molecolari e Scienze della Salute dell'Università di Torino organizza un workshop di un giorno il 10 novembre 2025.
Il workshop, intitolato "Mucins, Mucus and Mucosa - A Multidisciplinary Perspective across Biology, Biotechnology and Biomaterials", è un evento multidisciplinare che riunisce ricercatori provenienti da diversi settori, tra cui biologia, biotecnologie e biomateriali.
I seguenti relatori sono elencati come partecipanti allo studio: Alessandra Ghigo (UNITO), Daniela Pacheco (CEO dello spin-off Bac3Gel LDA, di cui la prof.ssa Livia Visai del Dipartimento di Medicina Molecolare dell'Università di Pavia è co-fondatrice e co-supervisore) e Olivier Lieleg (TUM).
La partecipazione all'evento è gratuita, tuttavia è richiesta la registrazione entro il 20 ottobre 2025.
Maggiori dettagli nella locandina.
***
The Department of Molecular Biotechnology and Health Science at the University of Turin is organising a one-day workshop on 10^(th) November 2025.
The workshop, titled "Mucins, Mucus and Mucosa - A Multidisciplinary Perspective across Biology, Biotechnology and Biomaterials", is a multidisciplinary event that brings together researchers from a range of fields, including biology, biotechnology and biomaterials.
The following speakers are listed as participants in the study: Alessandra Ghigo (UNITO), Daniela Pacheco (CEO of the spin-off Bac3Gel LDA, whose prof. Livia Visai of Department of Molecular Medicine of the University of Pavia is the co-founder and co-supervisor) and Olivier Lieleg (TUM).
Participation in the event is complimentary, however, registration is required and must be completed by 20^(th) October 2025.
To register, please use the QR code displayed on the flyer.
More details in the flyer.




